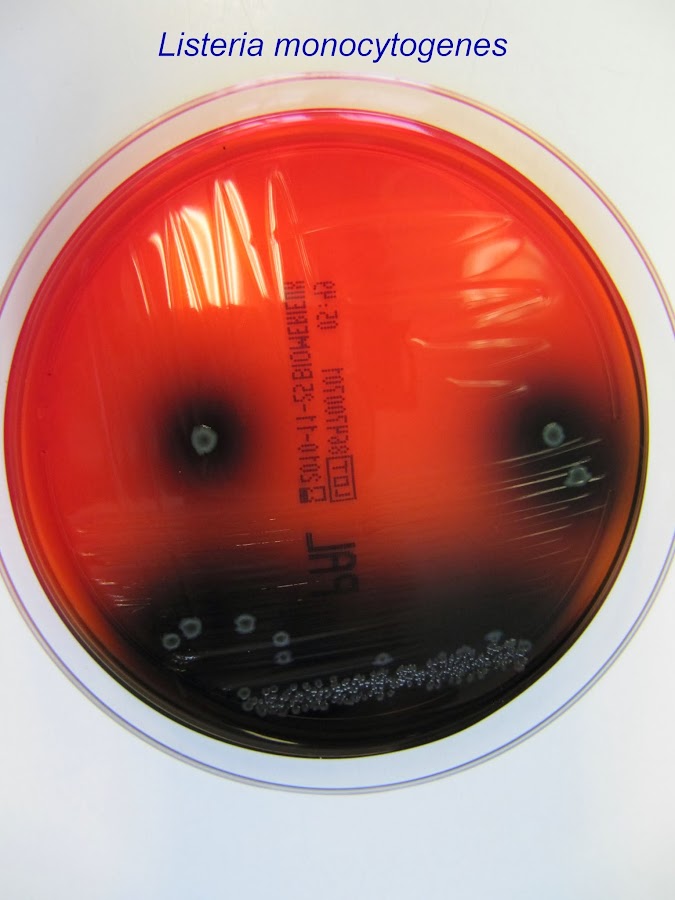

(Mahatma Gandhi)
MICROBIOLOGÍA DE LOS ALIMENTOS
(Parte 7)
ETA: Clasificación y características de los principales patógenos microbianos
Las Enfermedades Transmitidas por Alimentos se conocen desde épocas muy remotas. En el 2000 A.C, Moisés había dictado leyes sobre los alimentos que se podían comer y los que se debían rechazar, así como también estaban legislados los métodos de preparación y la importancia de la limpieza de las manos antes de ingerir los alimentos. Generalmente los relatos de intoxicaciones alimentarias que registra la historia antigua se atribuían a productos químicos venenosos, a veces incorporados deliberadamente. Recién en el siglo XIX se tuvo conocimiento de las enfermedades alimentarias producidas por gérmenes. Antiguamente se relacionaban los alimentos contaminados con el estado de putrefacción de los mismos. Hoy se sabe que los alimentos contaminados con microorganismos pueden tener aspecto, olor y sabor normal. Antony van Leeuwenhoek, un científico holandés que en 1674 observó, en una gota de agua de un lago, a través de varios lentes que formaban un primitivo microscopio, la presencia de pequeños organismos en forma de bastones. En una carta del 7 de setiembre de ese año, describió lo que había visto a través de su novedoso artefacto: “Extraje agua de un lago y, examinándola detenidamente, encontré flotando ahí dentro unas partículas terrosas y algunas rayas verdosas enrolladas en forma de espiral y ordenadamente acomodadas. La circunferencia entera de cada una de estas rayas estaba sobre el grueso de un pelo de una de sus cabezas, todas consistentes de glóbulos verdes muy pequeños que permanecían juntos”.
Sus dibujos reflejaron que se trataba de las primeras bacterias descriptas; sin embargo, sus descubrimientos no fueron tomados en cuenta en aquella época. Sólo doscientos años después, cuando Luis Pasteur demostró el papel que jugaban las bacterias en las fermentaciones de vinos y de cervezas, se apreciaron estos hallazgos. Pasteur investigó enfermedades en animales y hombres demostrando que las mismas eran causadas por bacterias. También observó que, si los alimentos eran esterilizados a través de una rigurosa cocción, se producía la muerte de la bacteria y el alimento sólo podía recontaminarse por razones externas (utensilios, manipulaciones, etc.). Al descubrirse el modo de difusión de estas enfermedades se empezaron a aplicar métodos de prevención y tratamiento. En el año 1854 John Snow descubrió que el agua contaminada podía favorecer la difusión del cólera. Años más tarde se descubrió en Suiza que la fiebre tifoidea también era vehiculizada por el agua. A fines del siglo XIX se vio que la leche participaba en la difusión de importantes enfermedades, introduciéndose la pasteurización (tratamiento que destruye las bacterias nocivas). En el año 1888 fue aislada por primera vez una bacteria causante de un brote de intoxicación alimentaria por consumo de carne cocida. A principios del siglo XX fueron descubiertas otras bacterias (Salmonellas, Staphylococcus, etc). Una defectuosa preparación, cocción o almacenamiento de un alimento, son las principales causas para la aparición de las bacterias en cualquier plato de comida, que comienzan a multiplicarse y hacen que el consumo del alimento sea peligroso para la salud. La presencia de bacterias no siempre se hace visible en los alimentos, no siempre presentan cambios de sabor, olor o, incluso, alteraciones en su aspecto. El objetivo de la higiene en este sentido es garantizar la producción y elaboración de alimentos que sean inocuos y limpios.
Si se revisan las causas de cómo se produjo una ETA, pueden encontrarse los siguientes factores:
1. Enfriamiento inadecuado.
2. Preparación con demasiada anticipación al consumo.
3. Almacenamiento inadecuado.
4. Conservación a temperatura ambiente.
5. Cocción insuficiente. (temperaturas inadecuadas de cocción)
6. Conservación caliente a temperatura inadecuada.
7. Higiene personal insuficiente.
8. Contaminación cruzada.
9. Ingredientes de origen dudoso.
10. Contacto de alimentos con animales y/o sus excrementos.
La Organización Mundial de la Salud (OMS), ha definido a la ETA como “Enfermedad de carácter infeccioso o tóxico que es causada, o que se cree que es causada, por el consumo de alimentos o de agua contaminada”.
El Comité de Expertos de la OMS analizó que la mayoría de las enfermedades por alimentos son de origen microbiano, que tal vez sea el problema más extendido en el mundo contemporáneo y una causa importante de la reducida productividad económica. Según los investigadores de la OMS, las ETA constituyen una patología con una proporción de personas en condiciones de contraer la enfermedad que alcanza a todos los estratos poblacionales, es decir que todos somos susceptibles a las enfermedades causadas por alimentos contaminados. La Organización estima que cada año mueren 1 millón de niños menores de 5 años en países en vías de desarrollo, lo que implica 2.700 decesos por día. Según el Comité de Expertos, en América Latina durante el año 2013 se reportaron más de 500 brotes de ETA, los cuales ocurrieron en un 40 % en el ámbito doméstico y sólo un 9 % en puestos callejeros y restaurantes.
Las Enfermedades Transmitidas por Alimentos pueden generarse a partir de un alimento o de agua contaminada. Son llamadas así porque el alimento actúa como vehículo de transmisión de organismos dañinos y sustancias tóxicas. Un brote de ETA se da cuando dos o más personas sufren una enfermedad similar después de ingerir un mismo alimento y los análisis epidemiológicos señalan al alimento como el origen de la enfermedad, que luego es confirmado por el laboratorio.
Las ETA(s) pueden manifestarse a través de:
a. Infecciones transmitidas por alimentos: son enfermedades que resultan de la ingestión de alimentos que contienen microorganismos perjudiciales vivos. Por ejemplo: salmonelosis, hepatitis viral tipo A y toxoplasmosis.
b. Intoxicaciones causadas por alimentos: ocurren cuando las toxinas o venenos de bacterias o mohos están presentes en el alimento ingerido. Estas toxinas generalmente no poseen olor o sabor y son capaces de causar enfermedades después que el microorganismo es eliminado. Algunas toxinas pueden estar presentes de manera natural en el alimento, como en el caso de ciertos hongos y animales como el pez globo. Ejemplos: botulismo, intoxicación estafilocócica o por toxinas producidas por hongos.
c. Toxiinfección causada por alimentos: es una enfermedad que resulta de la ingestión de alimentos con una cierta cantidad de microorganismos causantes de enfermedades, los cuales son capaces de producir o liberar toxinas una vez que son ingeridos. Ejemplos: cólera, estafilococosis.
Los síntomas varían de acuerdo al tipo de contaminación, así como también según la cantidad del alimento contaminado consumido. Los síntomas más comunes son vómitos y diarreas, también pueden presentarse dolores abdominales, dolor de cabeza, fiebre, síntomas neurológicos, visión doble, ojos hinchados, dificultades renales, etc. Según la Food and Drug Administration (FDA) del Gobierno de EE. UU. el 2% o 3% de ETA pueden llevar a una enfermedad de largo plazo. Por ejemplo, Escherichia coli O157: H7 puede provocar fallas en el riñón en niños e infantes, las Salmonelas pueden provocar artritis reactiva y serias infecciones y Listeria monocytogens puede generar meningitis o aborto. Sin embargo, existen malestares provocados por los alimentos que no se consideran ETA, como las alergias, las que no se pueden asociar con los alimentos que la provocan y que son los que han sufrido un proceso de fermentación (vinos, cerveza, quesos, yogur).
Para las personas sanas, la mayoría de las ETA son enfermedades pasajeras, que sólo duran un par de días y sin ningún tipo de complicación. Pero algunas ETA más graves pueden llegar a ser muy severas, dejar secuelas o incluso hasta provocar la muerte en personas susceptibles como son los niños, los ancianos, mujeres embarazadas y las personas enfermas. Los alimentos presentan siempre microorganismos en su superficie o en su interior. Estos microorganismos pueden ser, atendiendo a su origen, endógenos (ya presentes en el interior de las estructuras del alimento donde pueden provocar zoonosis, enfermedades animales no transmisibles al hombre y enfermedades vegetales no transmisibles al hombre) o exógenos (se incorporan al alimento durante su manipulación y procesado); y, atendiendo a su relación con el consumidor, pueden ser agentes patógenos o alterantes (saprófitos). Los agentes endógenos o son inocuos (patógenos de plantas) o son eliminados en mataderos (animales enfermos) o durante el procesado (pasteurización).
En cualquier caso, los alimentos son una vía importante de transmisión de microorganismos que pueden causar infecciones e intoxicaciones que, en general tienen un tiempo de incubación corto (2–10 hs) y suelen cursar con síndromes gastrointestinales. Puesto que algunas de estas patologías tienen una DMI (dosis mínima infectiva) muy baja es muy necesaria la higiene de los alimentos y de los procesos de elaboración. La incidencia real de las toxiinfecciones no está clara por que solo se declara un 10 % de estas enfermedades entre las que se encuentran salmonelosis, shigelosis o disentería bacilar, gastroenteritis por Escherichia coli enteropatógeno, enteritis causada por Yersinia enterocolitica, diarreas por Vibrio parahaemolyticus y por otros vibrios próximos al V. cholerae, enteritis causadas por Campylobacter, enteritis producidas por Bacillaceae, intoxicaciones alimentarias agudas como el botulismo (intoxicación por Clostridium botulinum) y la intoxicación estafilocócica, intoxicaciones alimentarias crónicas causadas por hongos, virosis transmitidas por alimentos como la hepatitis de tipo A, enfermedades causadas por protozoos y transmitidas por alimentos y enfermedades causadas por helmintos. Aisladamente cada una de las patologías anteriores puede prevenirse mediante un tratamiento adecuado del alimento; sin embargo hay que extremar este cuidado cuando se trata de producción de alimentos o comidas a gran escala puesto que en estas condiciones es más factible una contaminación que produce un elevado número de víctimas.
PLANES de MUESTREOS y CRITERIOS MICROBIOLOGICOS
En la elaboración de un alimento se pueden identificar una serie de pasos en los que puede producirse la contaminación del alimento por microorganismos o en los que los microorganismos ya presentes en el alimento pueden multiplicarse con mayor facilidad. Estos pasos del proceso se denominan “puntos críticos” y sobre ellos hay que actuar a la hora de mejorar las características microbiológicas del alimento en cuestión. Un producto tiene buena calidad microbiológica cuando sus cargas microbianas son reducidas y constantes (esto es, no presentan variaciones estacionales o de cualquier otro tipo de periodicidad que impiden que el producto sea homogéneo a lo largo del tiempo). Para lograr un aumento de la calidad microbiológica de un alimento lo que hay que hacer es determinar en la Industria cuáles son los puntos críticos del proceso y evitarlos siguiendo un código estricto de Buenas Prácticas de Elaboración y Distribución del alimento (BPE).
La prevención, por tanto, está en evitar manufacturar productos de baja calidad microbiológica y no en comprobar la calidad microbiológica de los ya elaborados (lo que, por otra parte, presenta una relación costo – beneficio muy baja por la gran cantidad de muestras que es necesario analizar). En el desarrollo de las BPE hay que hacer un análisis del riesgo consistente en determinar el peligro para la salud humana de un factor patógeno presente en un alimento y el medio como puede reducirse ese riesgo hasta valores infinitesimales por medios tecnológicos. Este riesgo depende de la DMI (Dosis Mínima Infectiva) del microorganismo y de los valores del mismo que se encuentren en el alimento; asimismo hay que valorar la carga inicial de microorganismos en cada una de las raciones del alimento, y el número de raciones o partes consumidas por la población en un determinado tiempo. La letalidad del tratamiento a aplicar viene dada por la fórmula:
l = log10(N0/Nc)
donde Nc son los valores aceptables del microorganismo a controlar y N0 la carga microbiana inicial para dicho microorganismo. Aplicando estas BPE las oscilaciones en la calidad microbiológica del producto disminuyen y el análisis microbiológico es más consistente puesto que permite detectar alejamientos de las BPE.
El análisis microbiológico de los alimentos no tiene carácter preventivo sino que simplemente es una inspección que permite valorar la carga microbiana. La prevención se logra como se indicó anteriormente. Puesto que el control microbiológico es un proceso analítico es necesario seguir una serie de criterios sobre la toma de muestras y el análisis microbiológico de los productos finales. En este sentido, es necesario considerar:
1) la distribución desigual de los microorganismos en los alimentos, lo que hace necesario seguir un esquema de toma de muestras para obtener resultados representativos;
2) que el número de criterios utilizados a la hora de juzgar la calidad microbiológica de los alimentos debe limitarse al mínimo necesario para así poder aumentar el número de análisis y
3) que los criterios de análisis aplicados han de ser específicos de cada alimento porque son diferentes los microorganismos patógenos y alterantes de cada tipo de alimento. Un protocolo de análisis de alimentos correcto debe considerar:
1) la heterogeneidad de la presencia de microorganismos en los alimentos,
2) el proceso de transporte de las muestras del sitio de recolección al laboratorio evitando la multiplicación de los microorganismos presentes o la inactivación de algún microorganismo;
3) que es necesario detectar bacterias que suponen entre 10-4 y 10-7 de la flora normal del alimento, flora ésta inocua, utilizando medios selectivos;
4) los tratamientos tecnológicos pueden producir daños subletales en los microorganismos que no pueden, en esas condiciones, ser sometidos rigurosamente a medios selectivos y es necesaria la utilización de medios de recuperación y
5) que, en cualquier caso, es necesario realizar una evaluación sistemática de los medios de cultivo para prevenir la variabilidad debida a pequeños errores en la preparación de los medios de cultivo.
El planteamiento del muestreo del alimento es diferente si se trata de un muestreo único (caso de una partida que llega por primera o única vez al centro de control microbiológico) del muestreo repetido. Cuando hay que hacer un muestreo de una partida única de alimento hay que considerar que los datos de mayor importancia los proporcionan las normas de elaboración y conservación del alimento. Ningún muestreo único puede dar una garantía total de calidad microbiológica del alimento y, como norma general, es conveniente analizar un número de muestras equivalente al 1% si el lote es grande y al 10% si es pequeño. En el caso de un muestreo repetido, un sistema basado en el análisis de 10 muestras al azar y rechazo del lote cuando se detecte una defectuosa obligará al fabricante a establecer medidas de seguridad suficientes para proteger adecuadamente al consumidor. En la rutina de trabajo del laboratorio no siempre es práctico; pensemos en lo engorroso que sería tomar el 10 % de un universo de 1000 latas de conserva, por ejemplo (100 latas). Nuestra experiencia personal, nos lleva a inferir que puede ser monitoreado con valores de muestras que no sobrepasen los 300 grs de cada efecto ser analizado (efectos a granel); en el caso de las conservas, se investigará una lata del lote recibido y tomada al azar, con un peso mínimo de 250 grs o su equivalente, teniendo la precaución de tomar aquellas latas que pudieran tener un índice macroscópico de sospecha, como ser: abolladuras, abultamientos, etc.
La muestra a analizar debe de ser tomada respetando las normas básicas de higiene y de esterilidad; para ello utilizaremos dos frascos de vidrio estériles con tapa metálica a rosca del tipo mermelada. De ser posible, tomar la muestra en el laboratorio y al lado de un mechero de Bunsen, utilizando plato y cubiertos de aluminio flameados con alcohol. De no ser posible éste procedimiento, se tomará la muestra in situ y flamearemos los utensilios antes mencionados con un hisopo embebido en alcohol. Ahora bien, al llegar al lugar de trabajo, la muestra obtenida (muestra madre), debe fraccionarse en dos partes (muestras de trabajo): en un frasco estéril pesaremos higiénicamente 10 grs de dicha muestra a los que añadiremos 90 ml de solución buffer de fosfato de sodio 9 N, diluida 1 ml de la misma, en 100 ml de agua destilada estéril. De no contar con éste tampón, se aconseja el uso de agua destilada estéril o de solución fisiológica estéril y no otras soluciones o diluyentes. Obtenemos así una dilución de la muestra madre de 1:10 y de allí partimos para investigar todos los microorganismos indicadores y patógenos, consignados en el Código Alimentario Argentino. Para la investigación del género Salmonella, debemos partir de una muestra de trabajo de 25 grs de la muestra madre, diluida en 225 de buffer fosfato o agua destilada estéril. NUNCA debemos desechar la muestra madre, la que se mantendrá convenientemente refrigerada hasta terminar con las marchas investigativas. Analizaremos ahora cómo y porqué se aplica el término de “criterio microbiológico” y daremos ejemplos de la realización de un plan de muestreo.
Un criterio microbiológico para alimentos define la aceptabilidad de un proceso, producto o lote de alimentos basándose en la ausencia o presencia o el número de microorganismos y/o la investigación de sus toxinas por unidad de masa, volumen o área. Un criterio microbiológico, según se detalla en "Principios para el Diseño y la Aplicación de Criterios Microbiológicos Para Alimentos" - Codex Alimentarius Commission, consiste en:
Señalar el alimento al que se aplicará el criterio,
Elección de microorganismos y/o sus toxinas/ metabolitos a identificar y la razón de la elección para el producto,
Un plan de muestreo indicando el número de muestras a tomar, el tamaño de la misma y las características de la unidad analítica,
Los métodos para su detección y/o cuantificación,
Los límites microbiológicos considerados apropiados para el alimento en el punto indicado de la cadena alimentaria,
El número de unidades analíticas donde se debe verificar el cumplimiento de dichos límites.
Al establecer un criterio microbiológico se tienen que tener en cuenta los siguientes factores:
Evidencia epidemiológica de que el alimento en cuestión es un vehículo significativo de enfermedad.
Susceptibilidad del alimento a ser contaminado por patógenos.
Probabilidad de crecimiento microbiano en el alimento durante su manufactura, almacenamiento, distribución y preparación.
Tratamiento que recibe el alimento antes de ser consumido (proceso de cocción, etc.).
La susceptibilidad de los probables consumidores a agentes patógenos y toxinas.
Para establecer un criterio microbiológico se debe definir previamente cuál será el propósito del mismo, éste puede comprender la evaluación de:
La inocuidad del alimento: para este propósito se requiere la determinación de microorganismos patógenos y/o toxinas y en algunos casos la utilización de microorganismos indicadores (relacionados con la presencia de un patógeno).
El cumplimiento de las Buenas Prácticas de Manufactura (BPM).
La utilidad de un alimento como ingrediente para un propósito determinado.
La vida útil de un alimento a fin de determinar su fecha de vencimiento.
La evaluación que se hace de la inocuidad de los alimentos y de su aptitud para el consumo humano a través del cumplimiento con el criterio microbiológico designado para el producto en cuestión, puede referir a ausencia de patógenos o a la demostración de la aplicación de Buenas Prácticas de Higiene. La comparación entre los resultados de laboratorio obtenidos y los criterios microbiológicos establecidos puede brindar información importante tanto para el productor/ elaborador como para los servicios de inspección en lo referente a la aceptabilidad del producto y / ó proceso. No basta con los criterios microbiológicos para lograr este objetivo, sino que es de suma importancia verificar la aplicación de las Buenas Prácticas de Manufactura u otros sistemas (por ejemplo, HACCP) para asegurar que los microorganismos indeseables sean eliminados o minimizados a un nivel tal que no puedan ocasionar daño a los seres humanos. En Argentina, el Código Alimentario Argentino establece dos categorías principales en cuanto a los criterios a seguir para la elaboración de patrones microbiológicos (provenientes de la Resolución M. S. y A. S. N° 003 del 11.01.95- de "Principios Generales Para El Establecimiento De Criterios Y Patrones Microbiológicos Para Alimentos MERCOSUR" - GMC - RES Nº 059/93):
Criterio obligatorio: se utiliza para referirse a los microorganismos considerados patógenos y/o sus marcadores, considerados de importancia en salud pública y de acuerdo con la clase de alimento. En este caso su hallazgo constituye razón suficiente para imputar la infracción y proceder en consecuencia, en forma preventiva o represiva, imponiendo las sanciones que correspondan.
Criterio complementario (recomendatorio): a diferencia del anterior es el criterio relativo a la evaluación del proceso tecnológico utilizado para la obtención de un producto. Puede orientar al fabricante, aconsejar acerca de puntos sin control, y su seguimiento permitirá inferir o determinar la "falla", que se demuestra en los protocolos analíticos. No tiene por finalidad la inspección final, con lo que se indica que de su incumplimiento no derivarán sanciones.
En ese momento se destacará la idoneidad del inspector actuante, quien sugerirá las acciones correctivas y se pondrá a prueba la responsabilidad del elaborador, a quien de de manifestarse remiso a adecuarse, sí se le aplicará la sanción correspondiente. Cuando se evalúa el riesgo microbiológico asociado a un alimento específico todos los microorganismos transmisibles a través de los alimentos deben ser considerados incluyendo bacterias, virus, hongos, levaduras, algas y parásitos. Los riesgos asociados como las toxinas/ metabolitos producidos por estos organismos y algunas propiedades intrínsecas (por ejemplo la resistencia a antibióticos) deben también ser considerados en la evaluación. La presencia de algunos microorganismos en los alimentos no es necesariamente un índice de riesgo para el consumidor. Vegetales y animales son la principal fuente de los alimentos que comemos y se encuentran naturalmente asociados a microorganismos, lo que implica que los alimentos que de ellos se obtengan también estarán asociados naturalmente a microorganismos.
Los microorganismos elegidos para la elaboración del criterio deben ser relevantes para el alimento y circunstancias particulares (producto crudo o listo para consumir, perfil del consumidor del producto). Si el criterio establece la búsqueda de microorganismos indicadores, su propósito debe ser detallado claramente (por ejemplo, detectar higiene inadecuada, indicar posible presencia de patógenos). Es importante tener presente que, mientras para un alimento cocido o listo para consumir la tolerancia para un determinado microorganismo es cero, sí se puede permitir la presencia del mismo en el alimento crudo – dentro de ciertos niveles- si éste fuera sometido a un tratamiento previo a su consumo por el cual se eliminará dicho microorganismo (por ejemplo, cocción). En este mismo sentido, la interpretación del resultado es diferente según se trate de producto crudo o producto cocido o listo para consumir.
"SOMOS LO QUE HACEMOS REPETIDAMENTE. EXCELENCIA, POR LO TANTO, NO ES UN ACTO SINO UN HÁBITO"
ARISTOTELES
LEGALES: El autor no asume responsabilidad alguna por la descarga, copia, distribución, modificación o alteración de los contenidos publicados, sean propios del mismo o de terceros, los cuales pudieren estar protegidos por Copyright, Derechos de Propiedad Intelectual, Derechos de Autor, o relacionados. La Bibliografía del tema expuesto y el crédito fotográfico está en poder del Autor y no se publica dada su extensión, pero se enviará por mail al interesado que la solicitare debidamente fundamentada.